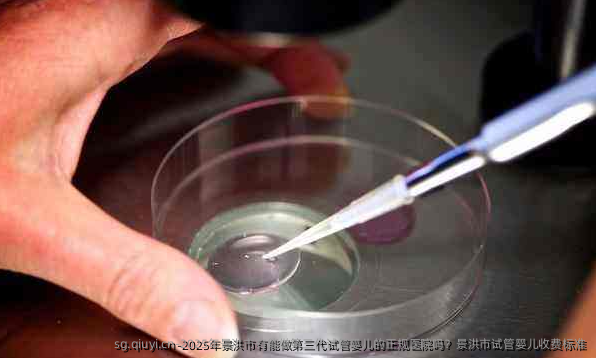

2025年,如果你想在景洪市做第三代试管婴儿,目前来看,景洪市本地可能还没有具备开展第三代试管婴儿技术的正规医院。这类技术对设备、医生经验以及实验室条件都有非常高的要求,通常只有在一些大城市的三甲医院或者专业的生殖医学中心才有。
开展人类辅助生殖技术的医疗机构
| 医院名称 | 医院地址 | 医院性质 |
| 普洱市人民医院妇女儿童医院 | 云南省普洱市思茅区茶苑路7号 | 公立医院 |
| 玉溪市人民医院 | 云南省玉溪市红塔区聂耳路21号 | 公立医院 |
| 云南九洲医院 | 云南省昆明市盘龙区联盟街道白云路229号 | 民营医院 |
注:数据来源网络,具体请依当地医院为准。
景洪市三代试管婴儿费用
景洪市地区三代试管的费用在9-12万元左右左右,每个医院的价格可能各有不同。
如果你想做第三代试管婴儿,可能需要考虑到云南省的昆明市或者其他一线城市,比如成都、重庆、广州、上海、北京等地。这些地方的生殖医学中心发展比较成熟,很多都已经具备了第三代试管婴儿的技术能力。
关于试管婴儿的收费标准,不同地区、不同医院的费用差别比较大。一般来说,第三代试管婴儿的费用相对较高,大致在8万到15万元人民币之间,具体费用会受到以下因素影响:
- 患者的身体状况,是否需要额外治疗
- 促排卵药物的种类和用量
- 是否需要进行胚胎冷冻或多次移植
- 医院的收费标准和所在城市消费水平
在景洪市,如果当地医院只能做第一代或第二代试管婴儿,那么费用会相对低一些,通常在3万到6万元人民币左右,但具体还得根据医院的实际收费情况来定。
如果你真的有这方面的需求,建议你提前做好准备,可以先在本地医院做一些基础检查,然后再到有资质的大医院进行进一步咨询和治疗。同时,也可以关注医保政策,看是否有一些费用可以报销,或者是否有相关的补助政策。
总之,景洪市目前可能还无法提供第三代试管婴儿服务,建议有需要的朋友尽早规划,前往技术更成熟的地区就医。费用方面也要提前了解清楚,做好心理和经济上的准备。

















